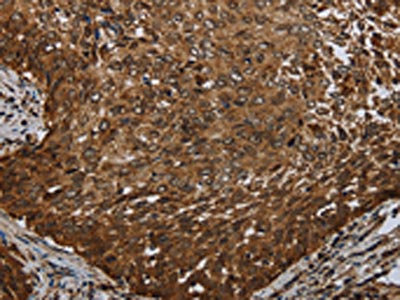

MT-ND3 Antibody
-
中文名稱:MT-ND3兔多克隆抗體
-
貨號:CSB-PA260526
-
規格:¥1100
-
圖片:
-
The image on the left is immunohistochemistry of paraffin-embedded Human colon cancer tissue using CSB-PA260526(MT-ND3 Antibody) at dilution 1/20, on the right is treated with synthetic peptide. (Original magnification: ×200)
-
The image on the left is immunohistochemistry of paraffin-embedded Human cervical cancer tissue using CSB-PA260526(MT-ND3 Antibody) at dilution 1/20, on the right is treated with synthetic peptide. (Original magnification: ×200)
-
-
其他:
產品詳情
-
Uniprot No.:
-
基因名:
-
別名:MT-ND3; MTND3; NADH3; ND3; NADH-ubiquinone oxidoreductase chain 3; NADH dehydrogenase subunit 3
-
宿主:Rabbit
-
反應種屬:Human
-
免疫原:Synthetic peptide of Human MT-ND3
-
免疫原種屬:Homo sapiens (Human)
-
標記方式:Non-conjugated
-
抗體亞型:IgG
-
純化方式:Antigen affinity purification
-
濃度:It differs from different batches. Please contact us to confirm it.
-
保存緩沖液:-20°C, pH7.4 PBS, 0.05% NaN3, 40% Glycerol
-
產品提供形式:Liquid
-
應用范圍:ELISA,IHC
-
推薦稀釋比:
Application Recommended Dilution ELISA 1:1000-1:2000 IHC 1:25-1:100 -
Protocols:
-
儲存條件:Upon receipt, store at -20°C or -80°C. Avoid repeated freeze.
-
貨期:Basically, we can dispatch the products out in 1-3 working days after receiving your orders. Delivery time maybe differs from different purchasing way or location, please kindly consult your local distributors for specific delivery time.
-
用途:For Research Use Only. Not for use in diagnostic or therapeutic procedures.
相關產品
靶點詳情
-
功能:Core subunit of the mitochondrial membrane respiratory chain NADH dehydrogenase (Complex I) which catalyzes electron transfer from NADH through the respiratory chain, using ubiquinone as an electron acceptor. Essential for the catalytic activity of complex I.
-
基因功能參考文獻:
- Disruption of FASTKD1 increases ND3 mRNA level. Disruption of FASTKD4 reduces it. Very low levels of FASTKD4 are sufficient to prevent ND3 loss. PMID: 28335001
- In the current study, we first took clinical and molecular datasets from case-control studies to determine the association between the ND3 G10398A mutation and breast cancer. PMID: 26782384
- Earlier age at onset was noted in male Chinese Machado-Joseph disease patients with MT-ND3 gene 10398A polymorphism PMID: 26336829
- The 10398G allele and Haplogroup I appear to confer significant protective effects for Fuchs endothelial corneal dystrophy PMID: 24917144
- Hypoxia, oxidative stress, and saturated fatty acids impacted mitochondrial-mediated cell apoptosis and had promotion on MT-ND3 expression in hepatocytes. PMID: 24020820
- Point mutations m.10191T>C in mitochondrial ND3 gene, m.13513G>A in ND5 gene and m.14,453G>A in ND6 gene were detected in three Chinese children with Leigh synrome dur to complex I deficiency. PMID: 22947169
- this short clinical review we evaluate the case reports of the m.10191T>C mutation causing complex I-deficient Leigh syndrome described in the literature. PMID: 22364517
- mitochondrial ND3 gene mutation may have a role in causing in Leigh syndrome with early lethality PMID: 14764913
- This is the first description of infantile Leigh syndrome due to a maternally transmitted T10191C substitution in ND3 and not due to a de novo mutation. PMID: 16023078
- These results show that the 10197G>A mutation in the mitochondrial ND3 gene should be considered as a common mtDNA mutation responsible for Leigh syndrome and dystonia. PMID: 17152068
- study reports a novel heteroplasmic m.10197G>A mutation in the ND3 gene in three Korean children with bilateral basal ganglia lesions and partial deficiencies of respiratory chain complex I activity PMID: 17413873
- These findings suggest that the clinical presentations associated with the mtND3*10197A (m.10197G>A) mutation (ND3) are much wider, encompassing those of LDYT and Leigh syndrome. PMID: 19458970
- 2 cases with a MELAS-like phenotype with additional unique features of epilepsia partialis continua accompanied by evolving lesions of the rolandic & calcarine cortices; both carried mutations in the MT-ND3 gene -- mt.10158T>C & mt.10191T>C PMID: 19520270
- mutations in the ND3 and ND5 genes in patients showing clinical features of mitochondrial encephalomyopathy, lactic acidosis, and stroke-like episodes PMID: 19617458
顯示更多
收起更多
-
相關疾病:Leigh syndrome (LS); Mitochondrial complex I deficiency (MT-C1D)
-
亞細胞定位:Mitochondrion inner membrane; Multi-pass membrane protein.
-
蛋白家族:Complex I subunit 3 family
-
數據庫鏈接:
Most popular with customers
-
YWHAB Recombinant Monoclonal Antibody
Applications: ELISA, WB, IHC, IF, FC
Species Reactivity: Human, Mouse, Rat
-
Phospho-YAP1 (S127) Recombinant Monoclonal Antibody
Applications: ELISA, WB, IHC
Species Reactivity: Human
-
-
-
-
-
-